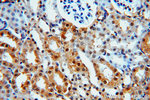
MYST2 Antibody in Immunohistochemistry (Paraffin) (IHC (P))

Search
Proteintech
MYST2 Polyclonal Antibody
{{$productOrderCtrl.translations['antibody.pdp.commerceCard.promotion.promotions']}}
{{$productOrderCtrl.translations['antibody.pdp.commerceCard.promotion.viewpromo']}}
{{$productOrderCtrl.translations['antibody.pdp.commerceCard.promotion.promocode']}}: {{promo.promoCode}} {{promo.promoTitle}} {{promo.promoDescription}}. {{$productOrderCtrl.translations['antibody.pdp.commerceCard.promotion.learnmore']}}
产品信息
13751-1-AP
种属反应
已发表种属
宿主/亚型
分类
类型
抗原
偶联物
形式
浓度
规格
纯化类型
保存液
内含物
保存条件
运输条件
产品详细信息
Immunogen sequence: MPRRKRNAG SSSDGTEDSD FSTDLEHTDS SESDGTSRRS ARVTRSSARL SQSSQDSSPV RNLQSFGTEE PAYSTRRVTR SQQQPTPVTP KKYPLRQTRS SGSETEQVVD FSDRETKNTA DHDESPPRTP TGNAPSSESD IDISSPNVSH DESIAKDMSL KDSGSDLSHR PKRRRFHESY NFNMKCPTPG CNSLGHLTGK HERHFSISGC PLYHNLSADE CKVRAQSRDK QIEERMLSHR QDDNNRHATR HQAPTERQLR YKEKVAELRK KRNSGLSKEQ KEKYMEHRQT YGNTREPLLE NLTSEYDLDL FRRAQARASE DLEKLRLQGQ ITEGSNMIKT IAFGRYELDT WYHSPYPEEY ARLGRLYMCE F (1-370 aa encoded by BC032640)
靶标信息
This gene encodes a member of the hepatoma-derived growth factor family. The encoded protein has mitogenic and DNA-binding activity and may play a role in cellular proliferation and differentiation. This gene was thought initially to be located on chromosome X, however, that location has been determined to correspond to a related pseudogene. Alternatively spliced transcript variants encoding distinct isoforms have been described.
仅用于科研。不用于诊断过程。未经明确授权不得转售。
生物信息学
蛋白别名: EC 2.3.1.48; HBO1; Histone acetyltransferase binding to ORC1; Histone acetyltransferase KAT7; histone acetyltransferase MYST2; K(lysine) acetyltransferase 7; Lysine acetyltransferase 7; MOZ, YBF2/SAS3, SAS2 and TIP60 protein 2; MYST family member; MYST histone acetyltransferase 2; MYST protein 2; MYST-2; unnamed protein product
基因别名: HBO1; HBOA; KAT7; MYST2; ZC2HC7
UniProt ID: (Human) O95251, (Rat) Q810T5, (Mouse) Q5SVQ0
Entrez Gene ID: (Human) 11143, (Rat) 303470, (Mouse) 217127